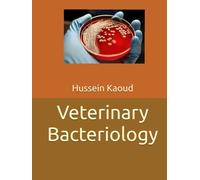
Veterinary Bacteriology

£46.03
amazon.co.uk
Free Delivery

£37.60
amazon.co.uk
Free Delivery

£159.97
Amazon-marketplace.co.uk
Free Delivery

The Veterinarian Who Took Roads Less Traveled: Stories and Essays on Family, Farming, Veterinary Medicine, and Public Health
£34.88
amazon.co.uk
Free Delivery

£99.99
amazon.co.uk
Free Delivery

Veterinary Public Health Officer Stainless Steel Insulated Tumbler
£18.20
amazon.co.uk
Delivery from £4.49

£45.24
Amazon-marketplace.co.uk
Free Delivery

Antimicrobial Resistance in Veterinary Medicine and Public Health
£56.53
Whsmith.co.uk
Free Delivery

MCQ in Veterinary Public Health & Epidemiology
£17.93
Amazon-marketplace.co.uk
Free Delivery

Salmonellosis and Fungal Diseases in Wild Animals: The presence of bacterial and fungal agents in reptiles and wild birds and their importance for public health
£30.00
amazon.co.uk
Free Delivery

Pet Hemp Aid Anxiety Spray 250ML | Instant Behavioral Aid | Purest Ingredients | Anti-Inflammatory Quick Absorb Calming Scent | Ideal for Cat & Dog
£9.99
39.96 GBP/1.0 l
Amazon-marketplace.co.uk
Delivery from £4.49

Pigs, Pets, and Public Health : One Veterinarian's Journey
£22.79
Whsmith.co.uk
Delivery from £3.99

Fictory Dog Anxiety Vest, Adjustable Calming Wrap for Thunder & Stress for Dogs, XL
£14.21
Amazon-marketplace.co.uk
Free Delivery

Safety of Dietary Supplements for Horses, Dogs, and Cats
£142.45
Whsmith.co.uk
Free Delivery

NICENEEDED 3 Pcs Service Dog Patches Set, Servcie Dog Tags for Harness, Dog Vest Harness Patches Removable Dog Tags Hook Backing Tags Easily Attach to Dog Collar for Small or Medium Working Dog
£6.68
Amazon-marketplace.co.uk
Delivery from £4.49

Milisten 36pcs Whelping Collars For Puppies: Multi-Color Litter Identification Puppy Kitten Collars - Adjustable Nylon Pet Id Bands For Newborn Dogs Cats
£9.89
Amazon-marketplace.co.uk
Free Delivery

£28.99
amazon.co.uk
Free Delivery

Service Dog Tag, Stress & Anxiety Response Patch and Paw Patch Hook & Loop for Dog Vest Harness(13)
£16.67
5.56 GBP/1.0 count
Amazon-marketplace.co.uk
Delivery from £5.34

Emotional Support Dog Card - Custom UK ESA ID with Dog Name, Handler Info & Emergency Contact - Durable Plastic with Mental Health Statement - Optional Dog Tags and Dog HI VIS Vest - AD66
£14.50
Amazon-marketplace.co.uk
Delivery from £1.99

£71.96
Amazon-marketplace.co.uk
Free Delivery

£63.95
amazon.co.uk
Free Delivery

£71.00
Amazon-marketplace.co.uk
Delivery from £2.80

Dog Carrier - Adjustable Shoulder Strap Pouch,Pet Bag Carrier | for Puppy Kitten Rabbits Travel Car Outdoor Public Transit Trips
£30.69
Amazon-marketplace.co.uk
Delivery from £1.99

GkgWuxf Dog Carrier Bag, Comfortable and Breathable Pet Carrier Pouch for Cats for Travel, Walking, Car, Puppies, Kittens, Outdoors, Public
£35.39
Amazon-marketplace.co.uk
Free Delivery

Dog Transport Bag, Scratch-Resistant and Non-Slip Bag, Puppy Transport Bag, for Puppies, Cats, Small Animals, Travel, Walks, Outdoor, Public Transport Excursions
£34.28
Amazon-marketplace.co.uk
Free Delivery

Dog Transport Bag - Breathable Resistant and Non-Slip Pet Transport Bag for Puppies Kittens Small Animals Travel Outdoor Walking Public
£36.99
Amazon-marketplace.co.uk
Free Delivery

Cat Carrier | Comfortable Breathable Pouch | Small Dog Carrier | for Puppy Kitten Rabbits Walk Car Outdoor Public Transit Trips
£35.39
Amazon-marketplace.co.uk
Free Delivery

Dog Ear Cover, Elastic Waterproof Scarf - Reinforced Pet Ear Cover - For Winter, Cold Climate, Outdoor Use, Travel, Veterinary Visit, Shower, Bath
£8.19
Amazon-marketplace.co.uk
Free Delivery

Dog Earmuffs | Waterproof Elastic Band, Reinforced Ear Protection | For Winter, Cold Climate, Outdoor Use, Travel, Veterinary Visit, Shower, Bath
£5.08
Amazon-marketplace.co.uk
Free Delivery

Dog Ear Cover - Elastic Waterproof Headband, Reinforced Ear Protection, Suitable for Winter Shower Bath Walks Travel Visit Veterinary Outdoor
£5.21
Amazon-marketplace.co.uk
Free Delivery

Dog Bag Carrier - Breathable Scratch-Proof Non-Slip Pouch - Dog Carrier Bag - for Travel Walk Car Outdoor Public Transit Trips Kitten Rabbits
£33.99
Amazon-marketplace.co.uk
Delivery from £2.99

Pet Ear Muffs - Soft Noise Cancelling Dog Earmuffs, Calming Hoodie Ear Protector for Large Dogs, Practical Feature for Grooming, Drying and Veterinary Visits, Loud Noise and Firework Details Pet
£9.89
Amazon-marketplace.co.uk
Free Delivery

Dog Bag Carrier | Scratch Proof Non Slip Pouch | Cat Carrier Pouch,for Travel Walk Car Puppy Kitten Outdoor Public Transit Trips Travel Trips
£26.36
Amazon-marketplace.co.uk
Delivery from £4.99

Pet Carrier, Shoulder Bag with Adjustable Strap - Carrier for Dogs, for Travel, Car Walks, Outdoor Public Transport Travel Trips
£37.09
Amazon-marketplace.co.uk
Delivery from £1.99

Pet Carrier | Breathable Scratch-Proof Non-Slip Pouch | Cat Carrier Pouch | for Travel Walk Car Puppy Kitten Outdoor Public Transit Trips Travel Trips
£30.99
Amazon-marketplace.co.uk
Delivery from £1.99

Dog Bag Carrier,Safe Comfortable Breathable Pouch,Puppy Carrier Bag - for Puppy Kitten Rabbits Walk Car Outdoor Public Transit Trips
£32.27
Amazon-marketplace.co.uk
Free Delivery

Pet Carrier Bag | Comfortable Breathable Pouch | Cat Carrier Pouch,for Puppy Kitten Rabbits Walk Car Outdoor Public Transit Trips
£16.98
Amazon-marketplace.co.uk
Delivery from £9.99

Dog Hat, Neck Warmer with Noise Protection | Pet Winter Hat with Adjustable Drawstring, for Daily Walking, Car Travel, Veterinary Visit, Holiday, Weather
£12.29
Amazon-marketplace.co.uk
Free Delivery

galeyyu Cat Carrier - Breathable Scratch-Proof Non-Slip Pouch,Dog Carrier Bag - for Puppy Kitten Rabbits Walk Car Outdoor Public Transit Trips
£30.99
Amazon-marketplace.co.uk
Delivery from £5.99
Veterinary Bacteriology
£60.00
amazon.co.uk
Free Delivery
- 1
- 2
- next page
🤖 Ask ChatGPT
🛍️ What are the most important purchase criteria?
💰 Tell me the best deals!
📋 Create a short summary!
Informations about "veterinary public health"
Compare 114 bids for your search.
Pricehunter was able to locate products in 17 categories, ranging from £5.08 to £757.84.
About "veterinary public health"
- In total, Pricehunter was able to locate 3 offers, from online shops such as Amazon-marketplace.co.uk, amazon.co.uk and Whsmith.co.uk.
- After having chosen your supplier you may also choose the delivery company. 7 delivery brands are available Springer Verlag, Generic Sports, Generisch and Generique being the most popular.
- The most bids (6) were found in the price range from £30.00 to £30.99.
- Customers who looked for this item also found interesting.
- With our extensive colour palette you can select your favourite colour for your article. Of the available 0 shades is the most frequently chosen.
Don't forget your voucher code:
Report Illegal Concerns
You are about to report a violation based on the EU Digital Services Act (DSA).